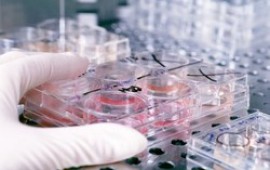
לראשונה: 5 חממות טכנולוגיות יופעלו ע"י יזמים

בתפקידה האחרון שימשה ד"ר קרדיש כמנהלת הפיתוח העסקי בחממת הטכניון. עם כניסתה לתפקיד היא אומרת: פעילות החממה תתמקד בשנים הקרובות באיתור והקמת חברות בתחום הטכנולוגיות החקלאיות
קבוצת טרנדליינס, בעלת החממות הטכנולוגיות מופ"ת ביהודה ומשגב בגליל, הודיעה השבוע על מינויה של ד"ר ניצה קרדיש לתפקיד מנכ"ל חממת מופ"ת. קרדיש הייתה עד לאחרונה מנהלת הפיתוח העסקי בחממת הטכניון ובעבר הייתה מנכ"ל חממת מדעי החיים של כלל ביוטכנולוגיה.
בפעילותה ההתנדבותית למען הקהילה מכהנת קרדיש בתפקיד יו"ר הוועד המנהל של יוזמות חינוך ימין אורד. קרדיש היא בעלת תואר דוקטור בביולוגיה מולקולארית של הצומח מאוניברסיטת ת"א ולמדה בפקולטה למשפטים באוניברסיטת ת"א.
עם כניסתה לתפקיד אמרה ד"ר קרדיש : "כבר היום, ובוודאי במהלך השנים הבאות, הדרישה לחדשנות בתחום הטכנולוגיות החקלאיות תלך ותגדל. הדבר נכון לגבי טכנולוגיות חקלאיות מסורתיות כגון ייעול במערכות השקיה, חקלאות מים וטיפוח זנים, ועד לטכנולוגיות מתקדמות בתחום הביו-חקלאי (AgBio) ומערכות תוכנה לניהול ידע ומשאבים. אני מאמינה שניתן למנף את עוצמת הידע האקדמאי והפרקטי שנמצא בישראל ולרתום אותו לטובת יזמות והקמת חברות מבטיחות בתחום זה. טרנדליינס בעלת החממה היא מהחברות המובילות בישראל בהשקעה בחברות בשלב הראשוני ("סיד") וקיבלנו החלטה אסטרטגית להשקיע בכיוון זה".
סטיב רודס, מנכ"ל קבוצת טרנדליינס ומבעליה: "קבוצת טרנדליינס מברכת את ניצה קרדיש עם כניסתה לתפקיד. ב- 2010 הוכרזה החממה שלנו במשגב על ידי המדען הראשי כחממה מצטיינת ובהובלתה של ניצה אנו מאמינים כי בתוך שנתיים-שלוש גם חממת מופ"ת תזכה בתואר הזה".
יוסי רון, שמסיים את תפקידו כמנכ"ל חממת מופ"ת, מתקדם לתפקיד סמנכ"ל תפעול בקבוצת טרנדליינס.